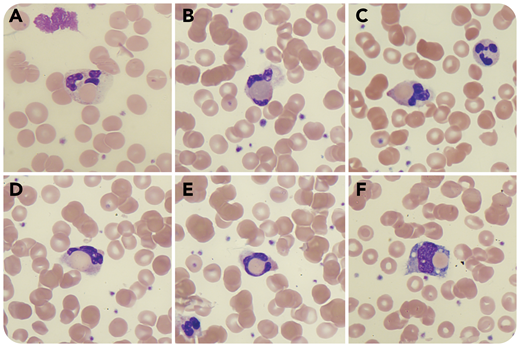
A 27-year-old man presented with fatigue, jaundice, and dark urine 10 days after an episode of high fever, cough, and diarrhea. Laboratory studies revealed hemolytic anemia with hemoglobin 5.9 g/dL, bilirubin 7.3 mg/dL (direct, 0.6 mg/dL), lactate dehydrogenase 1105 U/L (normal, 125-220 U/L), and low haptoglobin (<8 mg/dL). Direct Coombs test was positive for immunoglobulin M (IgM) and C3d, and a cold agglutinin test was negative. Blood smear revealed erythrophagocytosis by neutrophils (panels A-E; modified Wright's stain, original magnification ×100) and occasionally by monocytes (panel F; modified Wright's stain, original magnification ×100). A positive Donath-Landsteiner (DL) test confirmed the diagnosis of paroxysmal cold hemoglobinuria (PCH). Serology for mycoplasma pneumonia was highly positive (IgM, 1:1280). A diagnosis of IgM-mediated PCH due to mycoplasma pneumonia infection was made and the patient was treated with antibiotics and blood transfusions and was instructed to avoid cold.

A 27-year-old man presented with fatigue, jaundice, and dark urine 10 days after an episode of high fever, cough, and diarrhea. Laboratory studies revealed hemolytic anemia with hemoglobin 5.9 g/dL, bilirubin 7.3 mg/dL (direct, 0.6 mg/dL), lactate dehydrogenase 1105 U/L (normal, 125-220 U/L), and low haptoglobin (<8 mg/dL). Direct Coombs test was positive for immunoglobulin M (IgM) and C3d, and a cold agglutinin test was negative. Blood smear revealed erythrophagocytosis by neutrophils (panels A-E; modified Wright's stain, original magnification ×100) and occasionally by monocytes (panel F; modified Wright's stain, original magnification ×100). A positive Donath-Landsteiner (DL) test confirmed the diagnosis of paroxysmal cold hemoglobinuria (PCH). Serology for mycoplasma pneumonia was highly positive (IgM, 1:1280). A diagnosis of IgM-mediated PCH due to mycoplasma pneumonia infection was made and the patient was treated with antibiotics and blood transfusions and was instructed to avoid cold.
PCH is a rare disease that occurs mainly in children. Historically, it was seen with tertiary syphilis, but nowadays it is more commonly seen after a variety of infections, often viral, and rarely with lympho- and myeloproliferative disorders. DL antibodies make the definitive diagnosis of the disease. The antibodies are usually of the IgG type and very rarely of the IgM type. A blood smear showing erythrophagocytosis by neutrophils should raise the suspicion of PCH because of its strong association with this disease.
A 27-year-old man presented with fatigue, jaundice, and dark urine 10 days after an episode of high fever, cough, and diarrhea. Laboratory studies revealed hemolytic anemia with hemoglobin 5.9 g/dL, bilirubin 7.3 mg/dL (direct, 0.6 mg/dL), lactate dehydrogenase 1105 U/L (normal, 125-220 U/L), and low haptoglobin (<8 mg/dL). Direct Coombs test was positive for immunoglobulin M (IgM) and C3d, and a cold agglutinin test was negative. Blood smear revealed erythrophagocytosis by neutrophils (panels A-E; modified Wright's stain, original magnification ×100) and occasionally by monocytes (panel F; modified Wright's stain, original magnification ×100). A positive Donath-Landsteiner (DL) test confirmed the diagnosis of paroxysmal cold hemoglobinuria (PCH). Serology for mycoplasma pneumonia was highly positive (IgM, 1:1280). A diagnosis of IgM-mediated PCH due to mycoplasma pneumonia infection was made and the patient was treated with antibiotics and blood transfusions and was instructed to avoid cold.
PCH is a rare disease that occurs mainly in children. Historically, it was seen with tertiary syphilis, but nowadays it is more commonly seen after a variety of infections, often viral, and rarely with lympho- and myeloproliferative disorders. DL antibodies make the definitive diagnosis of the disease. The antibodies are usually of the IgG type and very rarely of the IgM type. A blood smear showing erythrophagocytosis by neutrophils should raise the suspicion of PCH because of its strong association with this disease.
For additional images, visit the ASH Image Bank, a reference and teaching tool that is continually updated with new atlas and case study images. For more information, visit http://imagebank.hematology.org.
This feature is available to Subscribers Only
Sign In or Create an Account Close Modal